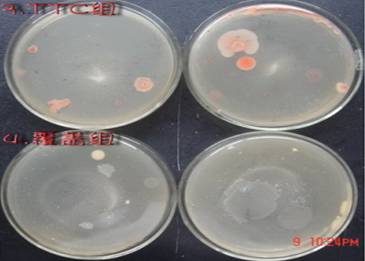

測菌落總數時,培養基經常出現成片的蔓延性菌,給后期計數帶來很大困擾,很多人都很惱火,本人嘗試了3種方法來解決這一問題,具體如下:

1組:常規法(對照組)
2組:陶瓦蓋組
3組:TTC組
4組:覆蓋組(如GB 4789.1推薦的加蓋一薄層)
大家可以看到:第一組形成很明顯的片狀菌落,其余三組的蔓延菌落都得到不同程度的緩解。
第二組加蓋陶瓦蓋,起到一個吸收瓊脂表面冷凝水的作用,防止細菌隨波逐流遷徙,但陶瓦蓋吸水能力太強,而導致平板周圍的瓊脂有干裂收縮現象發生。然而與通常的干裂平板不同的是,平板中央不會發生龜裂。
第三組,加了TTC后,顯色良好,便于辨認。
第四組,覆蓋一層薄薄的培養基后形成一個微需氧的環境還是能夠抑制蔓延菌落的形成的。
因為時間和精力有限,故未做大量樣品的驗證,本次實驗是一個新的嘗試,其結果不一定有統計學意義,但通過這一次隨機實驗,還是能夠得出三種方法均能有效防止蔓延菌落形成的映像。當你的實驗過程中出現類似情況時,不妨嘗試一下這三種方法。
總的來說,三種方法都比較有效,然而TTC和覆蓋組稍顯麻煩,陶瓦蓋組簡便卻又易造成平皿焦干,大家可以選擇自己合適的方法進行嘗試。